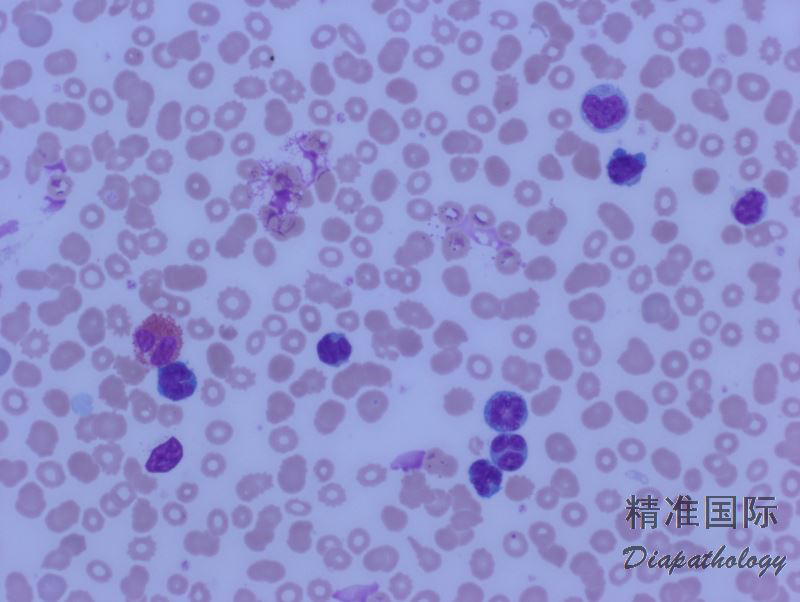
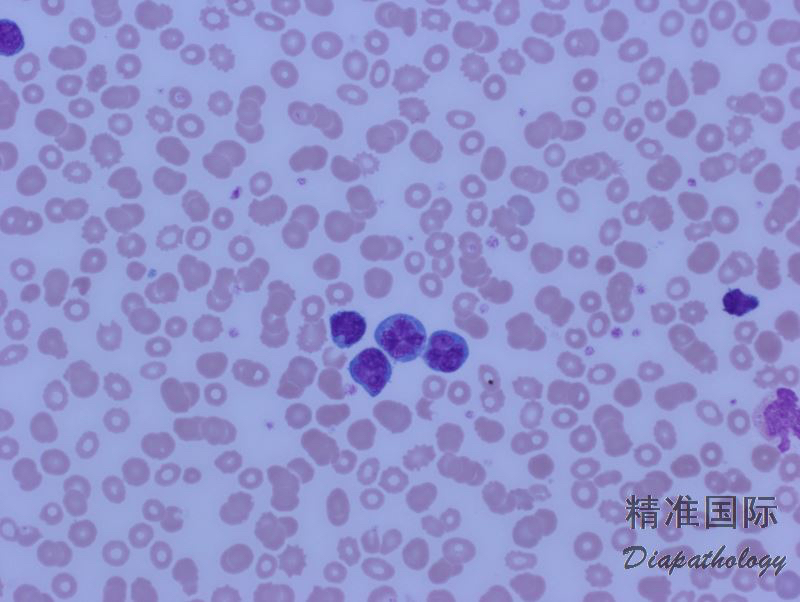

成人 T 细胞白血病/淋巴瘤
Adult T Cell Leukemia/Lymphoma, ATLL
概述:
ATLL 是一种成熟 T 细胞肿瘤,是由于感染人类 T 细胞白血病病毒(HTLV-1)所致,只发生于成人。肿瘤细胞核呈显著多形性,表达 T 细胞抗原 (大多病例表达 CD4,但通常不表达 CD7)。临床过程为侵袭性,常扩散累及多系统器官。
诊断要点:
主要发生于 HTLV-1 感染流行区,如日本。潜伏期长,幼年感染,发病多是成人。累及部位包括淋巴结、外周血、皮肤、肺、肝、消化道等。
临床表现有四种变异型:急性型(外周血肿瘤细胞显著增高和异型,高血钙)、淋巴瘤样型(淋巴结肿大为主,高血钙不定,外周血淋巴细胞不增高)、慢性型(外周血淋巴细胞轻度增高、皮疹,无高血钙)和焖燃型(外周血淋巴细胞无明显升高,异常细胞>5%,常有皮疹,无高血钙)。
外周血肿瘤细胞多少不等,从少量(焖燃型)到显著升高(急性型)。淋巴结类似白血病样侵润,窦内侵犯也常见。皮肤呈血管周围侵润,常累及表皮,有时真皮广泛侵润形成肿瘤结节并延至皮下。
肿瘤细胞形态大小多样,但急性型具有典型的细胞形态(多数患者在病程某阶段表现为急性型),其特点是多叶状细胞核如花瓣样,称为花样细胞;染色质致密、深染,但花样细胞通常无明显核仁;胞质嗜碱性,可见胞质空泡。有的病例(主要是慢性和闷燃型)淋巴细胞大小形态可类似正常淋巴细胞。
免疫表型:肿瘤细胞 CD3+,CD2+,CD5+,CD4+,CD25+,CD7-;极少数病例 CD4-/CD8+,CD4+/CD8+,CD4-/CD8-。
TCR 基因克隆性重排。最近研究发现有很多(多达 50 个)基因有重现性突变。

鉴别诊断:
蕈样肉芽肿和Sezary 综合症 (MF/SS):临床表现与慢性型和焖燃型 ATLL 类似,皮肤组织学也相近,但细胞核脑回样,没有典型花样细胞,CD25-,HTLV-1-。
T 幼淋巴细胞白血病 (T-PLL): 细胞核轻度不规则,常有中心核仁,无典型花样细胞,CD25-,HTLV-1-。
间变性大细胞淋巴瘤 (ALCL): 大型细胞,马蹄形或肾形核,CD30 染色一致强阳性,HTLV-1-。
预后:
急性型和淋巴瘤样型生存期从 2 周到超过 1 年。慢性型和闷燃型生存期较长,其中 2
